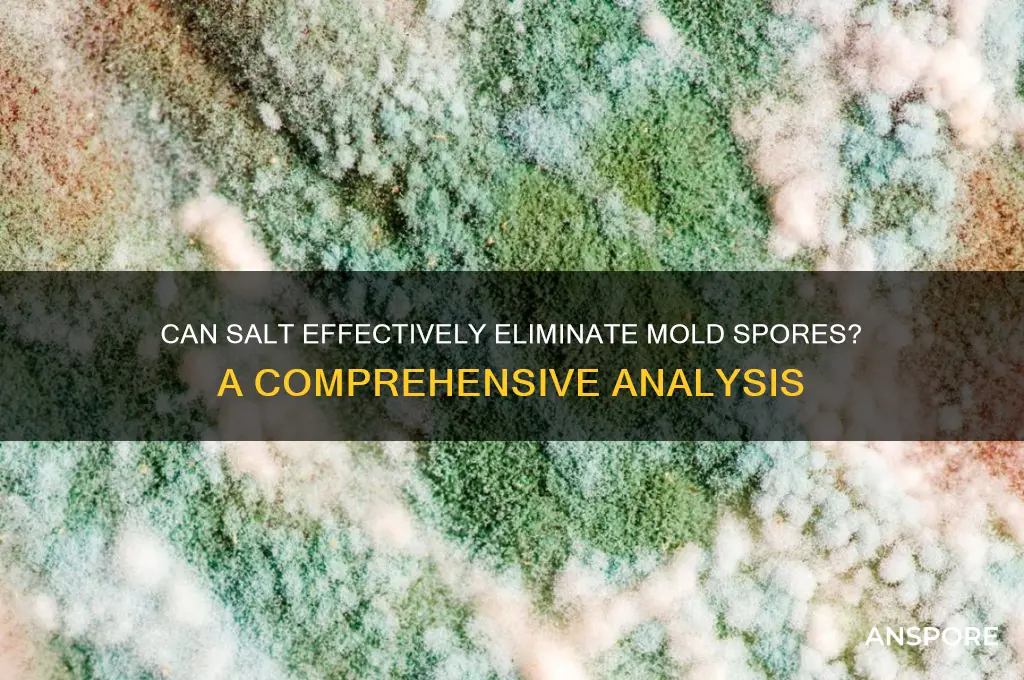
does salt kill mold spores

The question of whether salt can effectively kill mold spores is a common one, especially among those seeking natural remedies for mold control. While salt has been traditionally used as a desiccant and preservative due to its ability to absorb moisture, its effectiveness in eliminating mold spores remains a topic of debate. Mold spores are resilient microorganisms that thrive in damp environments, and while salt can dehydrate them by drawing out water, it may not always completely eradicate the spores. Some studies suggest that salt can inhibit mold growth by creating an inhospitable environment, but it may not be as potent as chemical treatments. Therefore, while salt can be a useful tool in preventing mold, its ability to kill spores entirely is limited, and it should be used in conjunction with other methods for comprehensive mold remediation.
| Characteristics | Values |
|---|---|
| Effectiveness on Mold Spores | Salt (sodium chloride) can inhibit mold growth by dehydrating cells through osmosis, but it does not effectively kill mold spores. Spores are highly resistant and require more aggressive methods like heat or specific chemicals for eradication. |
| Mechanism of Action | Acts as a desiccant, drawing moisture out of mold cells, which can prevent active growth but does not destroy spores. |
| Application Method | Can be applied directly as a dry powder or dissolved in water and sprayed on affected areas. |
| Suitability for Surfaces | Safe for most surfaces but may cause corrosion on metals or damage porous materials like wood over time. |
| Environmental Impact | Generally considered eco-friendly and non-toxic compared to chemical mold killers. |
| Longevity of Effect | Provides temporary mold suppression but does not offer long-term prevention without addressing moisture sources. |
| Limitations | Ineffective against deeply embedded spores; does not replace professional remediation for severe infestations. |
| Alternative Uses | Often used as a preventive measure in areas prone to moisture, such as basements or bathrooms. |
| Scientific Consensus | Widely acknowledged as a growth inhibitor but not a spore killer; spores require heat (above 140°F/60°C) or specific biocides for destruction. |
Explore related products
$13.48 $14.13
What You'll Learn

Salt's Dehydrating Effect on Mold Spores
Salt's dehydrating properties have long been recognized as a natural preservative, but its effectiveness against mold spores is a nuanced topic. When salt is applied to mold-prone surfaces, it works by drawing moisture out of the environment through a process called osmotic pressure. Mold spores require water to germinate and grow, so depriving them of moisture can inhibit their development. For instance, a 10% salt solution (approximately 100 grams of salt per liter of water) can create a hypertonic environment that forces water out of mold cells, effectively desiccating them. This method is particularly useful in areas with high humidity, where mold thrives.
However, the dehydrating effect of salt on mold spores is not absolute. While it can prevent active mold growth by removing necessary moisture, it does not necessarily kill dormant spores. Dormant spores are highly resilient and can survive in dry conditions, only reactivating when moisture returns. This means that while salt can be a preventive measure, it should not be relied upon as a sole solution for mold remediation. For example, in a bathroom prone to mold, applying a salt solution to tiles may temporarily inhibit growth, but without addressing the root cause of moisture, the mold will likely return.
To maximize salt’s dehydrating effect, it’s essential to apply it correctly. For surface treatment, dissolve 1 cup of table salt in 4 cups of warm water, and spray or wipe the solution onto affected areas. Allow the solution to dry completely, as this enhances its moisture-absorbing properties. For porous materials like wood or fabric, a paste made from salt and water can be more effective, as it allows for deeper penetration. However, caution should be exercised with sensitive materials, as salt can cause discoloration or damage over time.
Comparatively, salt’s dehydrating action is less aggressive than chemical mold killers but offers a safer, eco-friendly alternative. Unlike bleach or ammonia, salt does not release harmful fumes or leave toxic residues, making it suitable for households with children or pets. However, its effectiveness is limited to moisture control rather than spore eradication. For severe mold infestations, combining salt treatment with physical removal and ventilation improvements yields the best results.
In conclusion, salt’s dehydrating effect on mold spores is a practical, natural method for preventing mold growth in moisture-prone areas. While it does not kill dormant spores, its ability to create a dry environment inhibits active mold development. By understanding its limitations and applying it strategically, salt can be a valuable tool in the fight against mold. Always pair its use with proper ventilation and moisture management for long-term success.
Does Milky Spore Powder Work? Uncovering Its Effectiveness in Grub Control
You may want to see also

Types of Salt Effective Against Mold
Salt's efficacy against mold spores hinges on its ability to dehydrate and disrupt cellular function, but not all salts are created equal. Sodium chloride, or table salt, is the most accessible and commonly tested. A 20% salt solution, applied directly to affected surfaces, can inhibit mold growth by drawing moisture out of spores and hyphae. However, its effectiveness diminishes in high-humidity environments, where it may dissolve before achieving the desired effect. For best results, apply it to dry surfaces and reapply after 24 hours to ensure prolonged exposure.
For those seeking a more potent option, calcium chloride emerges as a superior alternative. Its hygroscopic nature allows it to absorb moisture more aggressively than sodium chloride, making it particularly effective in damp areas. Mix 1 part calcium chloride with 3 parts water and spray onto mold-prone surfaces. Caution: this salt is corrosive and should not be used on metal or sensitive materials. Its industrial strength makes it ideal for basements or crawl spaces but requires careful handling to avoid skin irritation.
Epsom salt, or magnesium sulfate, offers a gentler yet effective approach. While primarily known for its health benefits, its crystalline structure can puncture mold cell walls when applied as a paste (2 parts salt to 1 part water). This method is safe for use on garden soil to prevent mold on plants but may not be as effective on hard surfaces. Its mild nature makes it suitable for households with children or pets, though repeated applications are often necessary for stubborn infestations.
Comparatively, sea salt and Himalayan pink salt are less reliable due to their impurities and lower concentration of active compounds. While they may provide minor benefits, their inconsistent mineral content reduces their effectiveness against mold spores. For practical purposes, stick to refined salts with higher purity levels for predictable results. Always test any salt solution on a small area first to avoid surface damage, especially on porous materials like wood or fabric.
How Spores Shield Bacteria: Survival Strategies in Harsh Environments
You may want to see also

Application Methods for Mold Removal
Salt's efficacy against mold spores hinges on its desiccating properties, not antimicrobial action. While it won't directly kill spores, it can create an environment hostile to their growth by drawing moisture from their cellular structure. This makes salt a valuable tool in mold remediation, particularly in conjunction with other methods.
Understanding this mechanism is crucial for effective application.
Direct Application: For surface mold, a paste of salt and water can be applied directly. Mix 1 part salt with 2 parts warm water to form a thick paste. Spread this onto the affected area, ensuring complete coverage. Leave for 24-48 hours, allowing the salt to absorb moisture and dehydrate the mold. This method is best suited for non-porous surfaces like tiles, glass, or metal. After treatment, scrub the area with a brush and rinse thoroughly.
Aerial Dispersal: For mold in hard-to-reach areas or on porous materials, a salt solution can be sprayed. Dissolve 1 cup of salt in 1 gallon of warm water. Use a spray bottle to apply the solution liberally, focusing on areas prone to moisture accumulation. This method is particularly useful for preventing mold growth in bathrooms, basements, and areas with high humidity. Regular application can create an inhospitable environment for mold spores.
Caution: Avoid using salt solutions on delicate fabrics or surfaces that may be damaged by moisture.
Combination Therapy: For stubborn mold infestations, combining salt with other natural agents can enhance effectiveness. Mixing salt with vinegar, for example, creates a solution with both desiccating and acidic properties, further inhibiting mold growth. However, exercise caution when combining substances, as some combinations can be corrosive or produce harmful fumes. Always research compatibility and ventilate the area adequately.
Takeaway: While salt alone may not be a complete mold eradication solution, its desiccating properties make it a valuable tool in the fight against mold. By understanding its mechanism and employing appropriate application methods, salt can be effectively utilized for mold prevention and remediation, contributing to a healthier indoor environment.
Can Parasites Form Spores? Unveiling the Truth Behind Parasitic Reproduction
You may want to see also
Explore related products

Limitations of Salt in Killing Mold
Salt, while often touted as a natural remedy for mold, has significant limitations in its ability to kill mold spores effectively. Its primary mechanism involves dehydrating mold cells through osmosis, but this process is far from foolproof. Mold spores, being highly resilient, can enter a dormant state when exposed to salt, only to reactivate once the environment becomes favorable again. This means that while salt may temporarily inhibit mold growth, it does not guarantee long-term eradication. For instance, applying a 10% salt solution to a moldy surface might slow growth, but it won’t eliminate deeply embedded spores, leaving the root cause unaddressed.
One critical limitation is salt’s inability to penetrate porous materials like wood, drywall, or fabric. Mold thrives in these materials, where spores embed themselves deeply. Surface application of salt, even in high concentrations, fails to reach these hidden spores. For example, sprinkling salt on a moldy wooden beam might address visible mold but will leave spores within the wood intact. This superficial treatment often leads to recurring mold problems, as spores remain dormant until conditions allow them to flourish again.
Another drawback is salt’s potential to cause damage to surfaces and materials. When used in high concentrations or left for extended periods, salt can corrode metals, degrade wood, and discolor fabrics. For instance, applying salt to metal fixtures or painted surfaces can lead to rust or peeling. This makes salt a risky choice for treating mold in areas with sensitive materials, such as antique furniture or metal plumbing. Balancing mold treatment with material preservation becomes a challenge, limiting salt’s practicality in many scenarios.
Comparatively, salt falls short when measured against more effective mold-killing agents like bleach or vinegar. While bleach penetrates surfaces and kills spores on contact, salt merely suppresses growth temporarily. Vinegar, with its acidic properties, breaks down mold structures more effectively than salt. For example, a 5% vinegar solution can kill 82% of mold species, whereas salt’s efficacy remains inconsistent. This highlights salt’s role as a supplementary rather than primary treatment, best used in conjunction with other methods for optimal results.
In practical terms, relying solely on salt to kill mold spores is ill-advised. Instead, it should be part of a multi-step approach: first, remove visible mold with a scrub brush and detergent; second, apply salt as a dehydrating agent to inhibit residual growth; and finally, use a proven mold killer like bleach or vinegar to ensure spores are eradicated. For preventive measures, maintain humidity levels below 60% and ensure proper ventilation to discourage mold growth. While salt has its uses, its limitations underscore the need for a comprehensive strategy in mold remediation.
Can Ringworm Spores Contaminate Your Vacuum? Facts and Prevention Tips
You may want to see also

Salt vs. Commercial Mold Killers
Salt, a household staple, has long been touted as a natural remedy for various ailments, including mold. But how does it stack up against commercial mold killers? While salt can inhibit mold growth by drawing moisture out of the environment, it doesn’t actively kill mold spores. Commercial mold killers, on the other hand, contain biocides like bleach, hydrogen peroxide, or quaternary ammonium compounds, which are designed to destroy spores on contact. For surface mold, a solution of 1 cup of salt dissolved in 1 gallon of warm water can be applied to affected areas, but it’s more preventive than curative. Commercial products, when used according to label instructions, offer a more immediate and thorough solution, making them the better choice for active mold infestations.
Consider the application process: using salt requires time and patience. After applying a salt solution, it must be left to dry completely, which can take hours or even days depending on humidity levels. Commercial mold killers often act within minutes, allowing for quicker cleanup and reducing the risk of mold spreading. For example, a bleach solution (1 cup bleach per gallon of water) can be sprayed directly onto moldy surfaces, scrubbed, and wiped away in under 30 minutes. However, salt’s non-toxic nature makes it safer for households with children or pets, whereas commercial products may require ventilation and protective gear.
Cost is another factor. A 5-pound bag of salt costs around $1–$2, making it an affordable option for large areas or preventive maintenance. Commercial mold killers range from $5 to $20 per bottle, depending on the brand and concentration. While salt is budget-friendly, its effectiveness is limited to surface-level moisture control. Commercial products, though pricier, are formulated to penetrate porous materials like wood or drywall, targeting mold at its source. For minor mold issues, salt can be a practical first step, but for severe cases, investing in a commercial product is often necessary.
Environmental impact also differentiates the two. Salt is biodegradable and leaves no harmful residues, making it an eco-friendly choice. Commercial mold killers, particularly those containing bleach, can harm aquatic life if not disposed of properly and may contribute to indoor air pollution. For those prioritizing sustainability, salt offers a greener alternative, though its limited efficacy must be weighed against the urgency of the mold problem. Always test any solution on a small area first to avoid damage to surfaces.
In conclusion, the choice between salt and commercial mold killers depends on the severity of the mold issue, budget, and environmental concerns. Salt is ideal for preventive measures or minor surface mold, while commercial products are better suited for active infestations requiring immediate action. Combining both—using salt for maintenance and commercial killers for emergencies—can provide a balanced approach to mold control. Always follow safety guidelines and consider consulting a professional for extensive mold problems.
Growing Mushrooms from Spores: A Beginner's Guide to Cultivation
You may want to see also
Frequently asked questions
Salt can inhibit mold growth by dehydrating it, but it does not necessarily kill mold spores. Mold spores are highly resilient and can remain dormant until conditions become favorable for growth again.
Salt prevents mold growth by drawing moisture out of the environment through a process called osmosis, creating conditions that are unfavorable for mold to thrive.
Salt is not a long-term solution for eliminating mold spores. While it can temporarily suppress mold growth, spores can still survive and regrow once moisture returns. Professional remediation is recommended for persistent mold issues.































